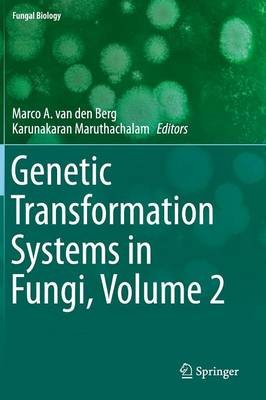

|
 Welcome to Loot.co.za!
Sign in / Register |Wishlists & Gift Vouchers |Help | Advanced search Welcome to Loot.co.za!
Sign in / Register |Wishlists & Gift Vouchers |Help | Advanced search
|
Your cart is empty |
||
You might also like..
Myxomycetes - Biology, Systematics…
Carlos Rojas, Steven L. Stephenson
Paperback
Microbiology of Atypical Environments…
Jack T. Trevors, Volker Gurtler
Hardcover
R4,634
Discovery Miles 46 340
Mycology, Plant Pathology, & Microbial…
B Bagyanarayana, B Bhadraiah, …
Hardcover
An Introduction to Mushroom
Ajit Kumar Passari, Sergio Sanchez
Hardcover
R3,322
Discovery Miles 33 220
Fungal Extracellular Vesicles…
Marcio Rodrigues, Guilhem Janbon
Hardcover
R4,920
Discovery Miles 49 200
|
||||||||||||||||||||||||||||||||||||